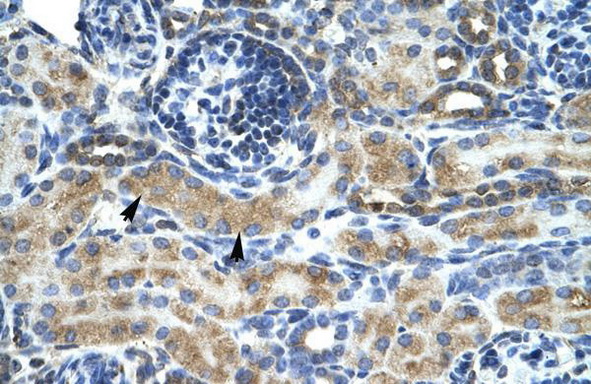

ZNF24 Rabbit Polyclonal Antibody
CAT#: TA333902
Rabbit Polyclonal Anti-ZNF24 Antibody
Need it in bulk or conjugated?
Get a free quote
CNY 4628.00
货期*
2周
规格
推荐一起购买 (4)
beta Actin Mouse Monoclonal Antibody, Clone OTI1, Loading Control
CNY 300.00
CNY 1430.00
Specifications
| Product Data | |
| Applications | IHC, WB |
| Recommend Dilution | WB, IHC |
| Reactivity | Human |
| Host | Rabbit |
| Clonality | Polyclonal |
| Immunogen | The immunogen for Anti-ZNF24 Antibody: synthetic peptide directed towards the middle region of human ZNF24. Synthetic peptide located within the following region: CDDDGRTENGALAPKQELPSALESHEVPGTLSMGVPQIFKYGETCFPKGR |
| Isotype | IgG |
| Formulation | Liquid. Purified antibody supplied in 1x PBS buffer with 0.09% (w/v) sodium azide and 2% sucrose. Note that this product is shipped as lyophilized powder to China customers. |
| Purification | Affinity Purified |
| Conjugation | Unconjugated |
| Storage Condition | Store at -20°C as received. |
| Predicted Protein Size | 42 kDa |
| Gene Name | zinc finger protein 24 |
| Database Link | |
| Background | ZNF24 is a new candidate transcription factor. |
| Synonyms | KOX17; RSG-A; Zfp191; ZNF191; ZSCAN3 |
| Note | Immunogen sequence homology: Dog: 100%; Pig: 100%; Rat: 100%; Horse: 100%; Human: 100%; Bovine: 100%; Rabbit: 100%; Guinea pig: 100%; Mouse: 92% |
| Reference Data | |
| Protein Families | Transcription Factors |
Documents
| Product Manuals |
| FAQs |
| SDS |
Resources
| 抗体相关资料 |
Customer
Reviews
Loading...